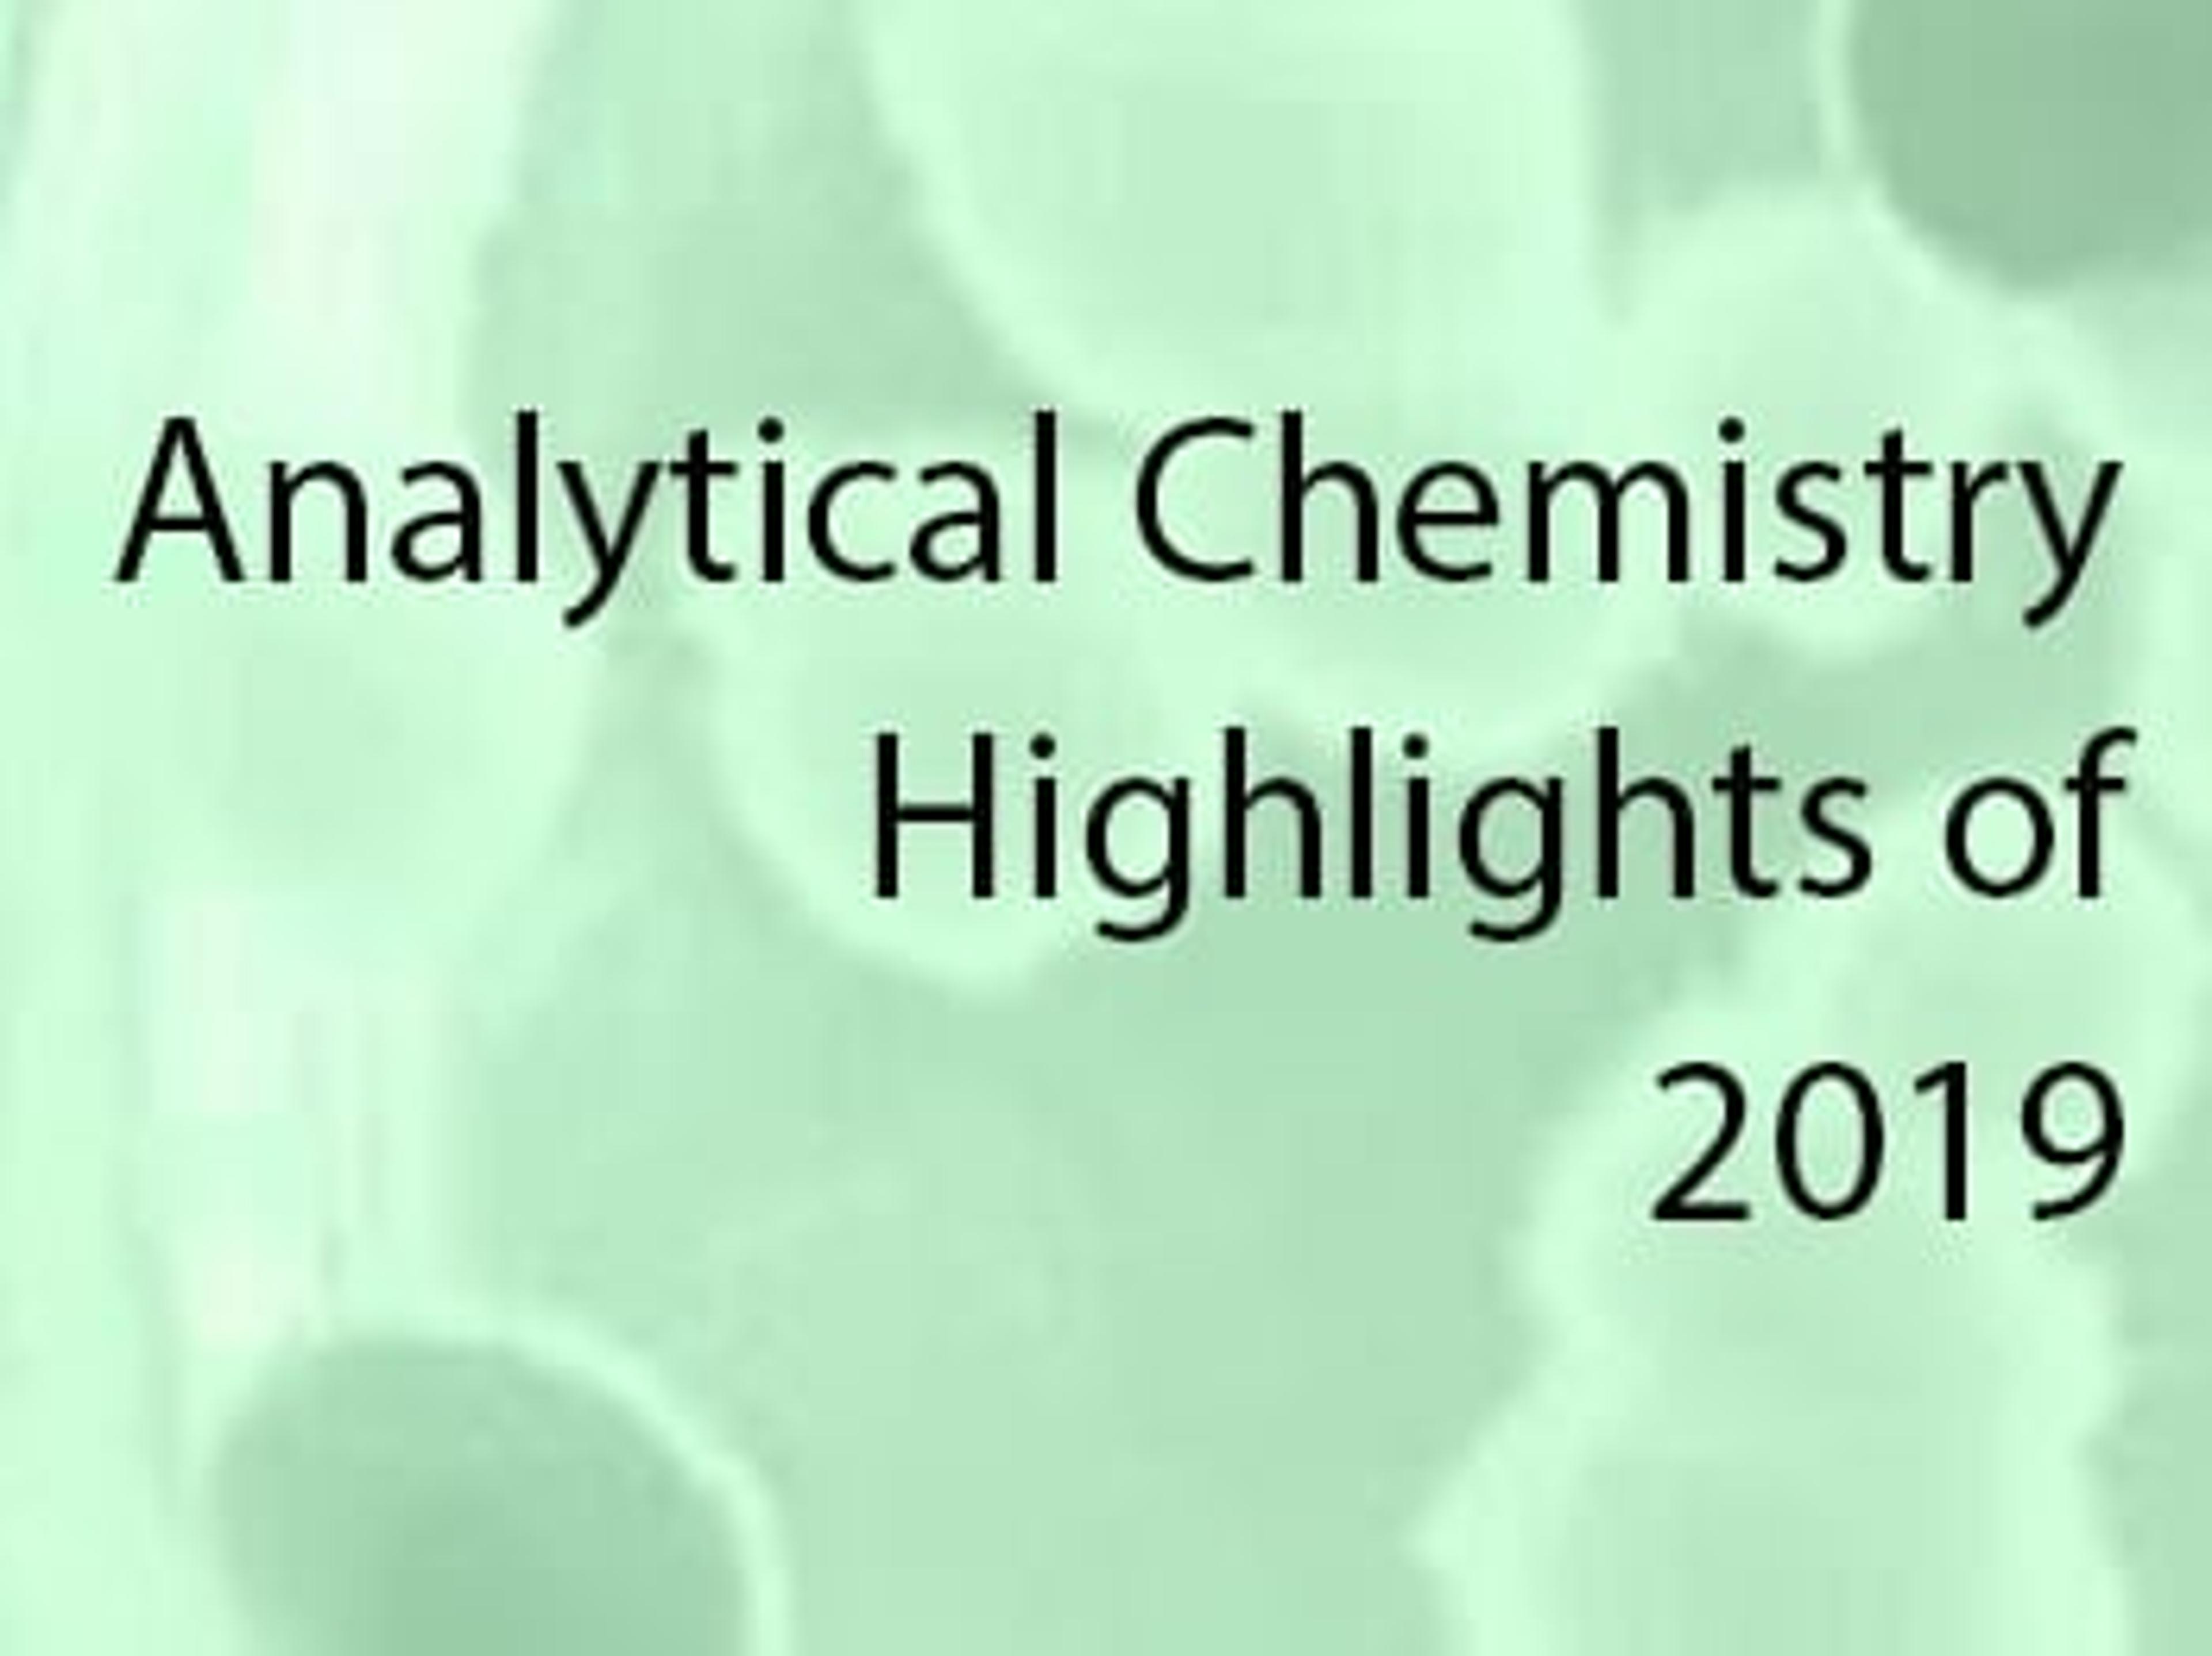

HX204 Moisture Analyzer
High-performance moisture analysis
Quick results.
Powdered mixes
Moisture analyzers have a vital role in food manufacturing especially in powdered mixes. It can be used without getting tired.
Review Date: 17 May 2021 | METTLER TOLEDO
A one-step moisture meter that is fast and accurate
moisture measurement
Covers a wide range of products and has results with in less than 10 min
Review Date: 30 Mar 2016 | METTLER TOLEDO
0.001 %MC (0.1mg) readability, user guidance, real-time drying curve, user management, method (300) & result (3000) storage, control charts, 4 drying programs, FACT, motorized lid.
Accurate Results for All Sample Types
Get highly reliable and repeatable moisture results thanks to fast halogen heating and superior weighing performance with high 0.001% MC readability.
Designed for Compliance
Smart compliance features to adhere to ALCOA+ principles with no original records on the moisture analyzer and automated export/printing functionality
Easy Connection via Multiple Interfaces
For easy reporting, connect the instrument to a PC, SFTP server, strip printer or network printer using either Ethernet, RS232 or USB.
Material No.: 30019875
Pharmaceutical quality control ensuring excellence and compliance
Pharmaceutical laboratories navigate rigorous guidelines and must maintain exhaustive documentation to ensure public health and meet regulatory compliance. Inefficient quality control can lead to significant operational setbacks, including product release delays, increased storage costs, regulatory penalties, and production bottlenecks.
Explore how modernized practices such as automation, data integrity, analytical service, quality control, and the importance of service and training are crucial for maintaining accuracy, efficiency, and compliance of pharmaceutical operations.
Additionally, learn about the advancements in personalized medicine and the enabling technologies that are shaping its development.
A comprehensive guide to master moisture analysis
Achieving accurate moisture analysis is crucial for maintaining product quality, shelf life, and performance across various industries.
This eBook provides an expert guide to mastering moisture analysis, highlighting the advantages of halogen moisture analyzers over traditional drying oven methods. It offers practical insights into ensuring reliable results through routine verification, effective cleaning techniques, and modernized digital record-keeping. Additionally, it explores moisture control strategies for food safety, manufacturing, and pharmaceuticals, emphasizing the importance of routine performance testing with advanced tools like SmartCal™.
Download your free copy to see how implementing these best practices can optimize your processes, enhance data accuracy, and improve overall product reliability.
Management of moisture data from paper to digital
Accurate moisture content analysis is essential for industries like food, pharmaceuticals, and chemicals to enhance product quality and profitability. Discover how Mettler Toledo halogen moisture analyzers offer fast, reliable measurements and advanced data-handling solutions, from manual transcription to automated processes, reducing errors and improving efficiency.
How to clean a moisture analyzer
Properly cleaning your moisture analyzer is crucial for maintaining accurate measurements, extending the instrument's lifespan, enhancing user safety, and minimizing the risk of cross-contamination. Explore effective cleaning methods and agents, find step-by-step instructions for cleaning your moisture analyzer, and discover five key solutions for maintaining optimal cleanliness.
Methods for halogen moisture analyzers
Discover how to optimize moisture analysis with halogen moisture analyzers. Explore ready-to-use methods for various samples, and step-by-step instructions for method development, ensuring accurate, repeatable results comparable to the drying oven procedure.
Moisture methods for the food industry
Moisture analysis plays a vital role in all areas of the food industry, from goods-in inspections, through quality control, production, and storage, to the development of new products. Explore this detailed guide on precise moisture content determination in food products using advanced thermogravimetric techniques. It highlights the advantages of Mettler Toledo Halogen Moisture Analyzers, including rapid and reliable measurements. Covering diverse samples like dairy, plant-based foods, and processed products, the guide ensures quality control and consistent results across the food industry.
A practical guide to drying oven versus halogen moisture analyzer
Moisture affects the quality, shelf-life and usability of many products, including pharmaceutical substances, plastics and foodstuffs. Therefore, monitoring and determination of the moisture content in samples is an important application. Typically, loss on drying (LOD) using a drying oven is used as reference method, but this can be slow with many manual steps. Faster determination of moisture content can be achieved with new methods, such halogen moisture analyzers (HMA), which are easy to use and give a direct result in a fraction of the time. The challenge has been how to validate the HMA method and prove that the results are comparable with the drying oven method.
Explore a detailed comparison between the drying oven and halogen moisture analyzer (HMA) methods for moisture content determination. With practical guides, real-world examples, and expert insights, this resource is essential for optimizing moisture analysis in industries such as pharmaceuticals, chemicals, and food production.
Essential Measurement Techniques: A Guide for Measurement Quality in the Lab
This guide provides helpful insights into essential measurement techniques such as weighing, pH measurement, pipetting and more, to help you improve the accuracy and efficiency of your day-to-day measurement tasks.
Measuring Moisture of Plastic Pellets
The moisture content of polyamides or polycarbonates is an important factor in product processing, appearance and properties. This application note demonstrates the accurate determination of moisture content in plastics with the Mettler Toledo HX204 Moisure Analyzer.
Moisture Method Compilation: Determining Moisture Content in 22 Different Food Types
Moisture analysis in the food industry is vital for quality control, storage, and goods-inspections. This comprehensive brochure compiles recommended moisture determination methods for 22 different food types, to achieve precise results in less time.
Understanding the basics of moisture determination for superior quality control
May 6, 2025 at 14:00 BST / 15:00 CEST / 09:00 EDT / 06:00 PDT
Moisture content is a critical factor that influences various aspects of a product, including its processability, shelf life, usability, and overall quality. This makes it an important factor to monitor accurately otherwise it can lead to inconsistencies in performance and even non-compliance with industry standards.
Learn how to effectively measure moisture content of your products in this informative webinar with Andrea Mühleis from METTLER TOLEDO. She will share insights to understand moisture determination and top tips to achieve accurate and reliable moisture results.
She will also highlight the differences between halogen heating technology and drying oven technology as well as how to correctly prepare samples for analysis to provide you with valuable strategies to optimize your moisture determination.
Key learning objectives:
- Explore the different methods used for moisture analysis
- Learn techniques for sample preparation in moisture analysis
- Discover the method development to match results from the drying oven
- Uncover what routine testing can be performed for moisture analyzers
Who should attend?
- Quality control professionals, laboratory technicians, analysts, and researchers in industries including food, pharmaceuticals, and chemicals, who require accurate moisture analysis for product quality and development.
- Production managers and academic researchers who need to understand moisture control techniques for manufacturing consistency and educational purposes.
Certificate of attendance
If you attend the live webinar, you will automatically receive a certificate of attendance, including a learning outcomes summary, for continuing education purposes.
If you view the on-demand webinar, you can request a certificate of attendance by emailing editor@selectscience.net.
Analytical chemistry round-up for 2019
Take a look back through 2019 at the best content from our analytical community
Latest Advancements in Biopharmaceutical Research and Technologies
Discover a range of new technologies and applications for biopharmaceutical development in this special editorial feature
Analytical Chemistry Highlights – Thermal Desorption, Solid Phase Extraction & Food and Flavor Analysis
Find out more about the hottest content you may have missed over the past month
7 Food & Bev Highlights: Flavor, Cookies, Caffeine & More
Catch up on all the tastiest news and developments in the Food & Beverage Community over the past month
Can Science Really Help Make the Best Cookies?
Ever wondered why some cookie recipes are better than others? In this article, discover the impact moisture content can have on taste, shelf-life and more